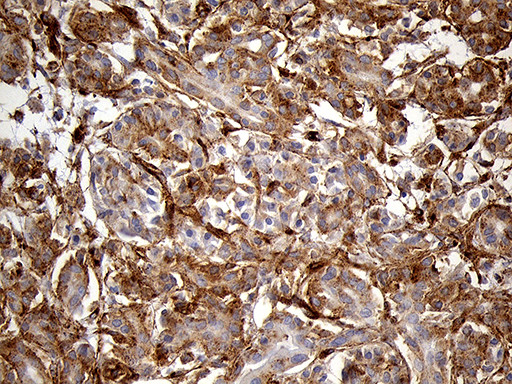
IFITM2 Antibody in Immunohistochemistry (Paraffin) (IHC (P))

Search
OriGene
IFITM2 Monoclonal Antibody (OTI3B1), TrueMAB™
{{$productOrderCtrl.translations['antibody.pdp.commerceCard.promotion.promotions']}}
{{$productOrderCtrl.translations['antibody.pdp.commerceCard.promotion.viewpromo']}}
{{$productOrderCtrl.translations['antibody.pdp.commerceCard.promotion.promocode']}}: {{promo.promoCode}} {{promo.promoTitle}} {{promo.promoDescription}}. {{$productOrderCtrl.translations['antibody.pdp.commerceCard.promotion.learnmore']}}
产品信息
TA811625
种属反应
宿主/亚型
分类
类型
克隆号
抗原
偶联物
形式
浓度
纯化类型
保存液
内含物
保存条件
运输条件
靶标信息
IFN-induced antiviral protein which inhibits the entry of viruses to the host cell cytoplasm, permitting endocytosis, but preventing subsequent viral fusion and release of viral contents into the cytosol. Active against multiple viruses, including influenza A virus, SARS coronavirus (SARS-CoV), Marburg virus (MARV), Ebola virus (EBOV), Dengue virus (DNV), West Nile virus (WNV), human immunodeficiency virus type 1 (HIV-1) and vesicular stomatitis virus (VSV). Can inhibit: influenza virus hemagglutinin protein-mediated viral entry, MARV and EBOV GP1,2-mediated viral entry, SARS-CoV S protein-mediated viral entry and VSV G protein-mediated viral entry. Induces cell cycle arrest and mediates apoptosis by caspase activation and in p53-independent manner.
仅用于科研。不用于诊断过程。未经明确授权不得转售。
篇参考文献 (0)
生物信息学
蛋白别名: Dispanin subfamily A member 2c; DSPA2c; ifm2; Interferon-induced transmembrane protein 2; Interferon-inducible protein 1-8D
基因别名: 1-8D; DSPA2c; IFITM2
UniProt ID: (Human) Q01629
Entrez Gene ID: (Human) 10581